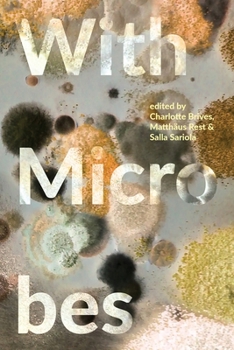
Paperback With Microbes Book

With Microbes
No Synopsis Available.
Format:Paperback
Language:English
ISBN:1912729180
ISBN13:9781912729180
Release Date:October 2021
Publisher:Mattering Press
Length:290 Pages
Weight:0.94 lbs.
Dimensions:0.7" x 6.0" x 9.0"
Customer Reviews
0 rating